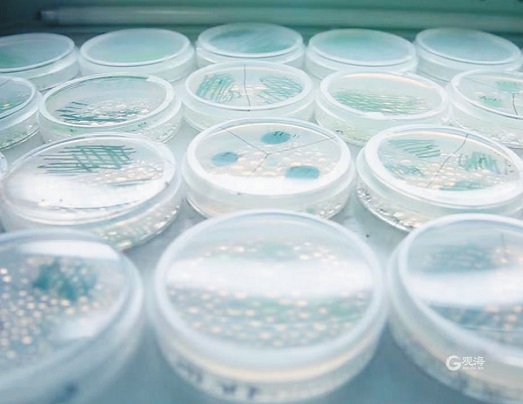
2.jpeg

当前位置 : 今日青島 - 國際日報
发布日期:2024/1/18
来源:
打印
财富聚焦
2023年青岛企业一级市场投融资案例占全省37%
青岛新兴产业成为“吸金”主力
直接融资规模再创新高
在刚刚过去的2023年,尽管创投市场呈现出保守和谨慎,青岛一级市场投融资依然取得了不错的成绩。
相较于公司上市后股票自由交易的二级市场而言,一级市场主要指企业通过创投风投等投资机构实现股权融资。相关数据统计显示,2023年,山东省至少有181个一级市场融资案例,其中青岛企业获投案例有67个,占比37%。2023年青岛辖区全年直接融资规模达1359亿元(不含企业在银行间市场发行债券融资额),较2022年增长98%,再创新高。

青岛金家岭金融区聚集了大量创投风投机构。
在青岛获投案例中,投资机构进一步向早期融资倾斜,并把目光集聚到新兴产业赛道。医疗健康、消费、集成电路和先进制造等行业成为“吸金”主力,映射出青岛产业发展的重点与未来。
“投早投小”成共识
青岛67起获投案例中,融资轮次覆盖天使轮到E轮,其中,32起案例获得天使轮至A轮的早期融资,占比近50%,反映了资本倾向于“投早投小”的趋势。另有9起为战略融资,数量仅次于A轮18起投资案例,意味着企业倾向于从产业协同角度引入对业务发展有重大影响的投资人。
从融资规模看,放眼全国,投资机构均趋于保守和谨慎。财联社统计数据显示,2023年融资金额不超过1亿元的投资案例占比最高,约36.6%;介于1亿元与10亿元之间的投资案例占比约9.14%,去年该区间占比约17.5%。在青岛获投案例中,除34起案例选择不披露融资金额外,融资规模主要集中在千万级,共有24起。这一方面与投资机构的谨慎有关,另一方面也与大部分融资发生在早期相关。
融资超亿元人民币的主要有青岛天仁微纳科技有限责任公司、青岛聚能创芯微电子有限公司等5家企业。“隐形冠军”青岛天仁微纳科技有限责任公司在本轮融资中获得数亿元融资,作为纳米压印设备和解决方案提供商,其在高精度纳米压印光刻设备细分领域技术国际领先,持续获得华为、中芯国际等头部企业的投资;获投1.7亿元的青岛聚能创芯微电子有限公司,主要从事第三代半导体硅基氮化镓(GaN)的研发生产,公司主打高性能、低成本的GaN功率器件产品和技术解决方案,为PD快充、智能家电、新能源汽车、光伏、5G通信等提供国产化核心元器件支持。
消费峰回路转
从投资领域看,青岛获融资案例的行业排名靠前的分别是医疗健康、消费、集成电路和先进制造,数量占比超六成,显示出新兴产业的吸金能力。
就全国而言,医疗健康也是热门板块,从2023年国内一级市场融资案例的数量来看,医疗健康排名第一。在青岛,2023年医疗健康融资案例有18个,同样位居首位。医疗健康在近两年表现出的快速成长令投资人欣喜,启明创投创始主管合伙人邝子平在日前举办的专业论坛上表示,医疗领域近两年正从量变迈向质变,在国际舞台上拥有强有力的竞争力。
由中科院青岛生物能源与过程研究所孵化的青岛中科蓝智生物科技发展有限公司,于2023年获得A+轮和战略融资,其从天然螺旋藻中提取的甘油葡糖苷纯度居于行业领先地位,在护肤和健康护理等领域应用广泛;完成数亿元B轮融资的青岛瑞斯凯尔生物科技有限公司,创建于2016年,专注于流式诊断领域,即通过对细胞进行分析测量诊断人体罹患的疾病,现已成为流式检测试剂医学相关领域的国内头部企业;获得数千万元天使轮融资的盘古机器人是医学教学与培训综合解决方案的提供者和引领者,公司产品包括医用机器人、手术模拟器、软件和课程等,主要用于医生、护士、医学生、院前急救人员培训,与多家全球医学模拟领导企业建立战略合作伙伴关系。
获投企业中科蓝智从天然螺旋藻中提取高纯度甘油葡糖苷。
与此同时,消费板块送走2022年至暗时刻,在2023年迎来峰回路转。上述统计案例中,青岛在消费板块的获投案例有10个。在提振消费、消费者更追求“质价比”等大背景下,新消费产品和企业层出不穷。
新中式预制菜品牌“面朝大海”获千万级Pre-A轮融资,品牌持有方青岛面朝大海科技有限公司成立于2020年,目前拥有面点、肉类、海鲜等预制菜产品线,主打食物鲜味,致力于为年轻消费者提供“一顿好饭”的解决方案。
以“水果+烘焙”作为独特理念的榴梿烘焙品牌榴小夏的母公司——青岛榴小夏餐饮管理咨询有限公司,获得数千万元的A轮融资。
聚焦新茶饮的荷田水铺(山东)餐饮管理有限公司和乐饮创新科技(青岛)有限公司分别获得Pre-A和股权融资,成立于2020年的荷田水铺在天使轮就获得梅花创投的青睐,在本次Pre-A轮融资中估值已经达到6.6亿元;精品咖啡工业化解决方案供应商乐饮创新科技在2022年获得5000万元A轮融资后,又在2023年获得两轮融资,其中盛景嘉成基金在2022年投资乐饮创新科技后,再次进行股权投资。据悉,创立于2011年盛景嘉成基金投资覆盖超过2500家全球创新创业项目,投资组合已涌现200家上市公司。
集成电路和先进制造的获投案例数量紧随其后,分别有8起和6起。致力于实现高端科学仪器和集成电路测试设备自主可控和国产替代的致真精密仪器(青岛)有限公司,于2023年获得A轮和Pre-A轮两轮融资,其中Pre-A轮为集成电路专业投资机构中芯聚源领投;核芯互联科技(青岛)有限公司获数亿元B轮融资,作为一家专注于数模混合信号链和时钟芯片设计的国家级专精特新“小巨人”企业,其具备从产品定义到量产的全流程能力,已成功为电力、个人计算、服务器、工业、汽车、轨交、新能源等各个领域的企业提供数模混合芯片解决方案。??
投融两端齐发力
一级市场活跃表现的背后,是青岛在提振实体经济以及创投风投投融资两端共同发力的结果。2023年,青岛围绕城市更新和城市建设、实体经济振兴发展、24条重点产业链打造、民营经济发展等持续发力,大力度培育优秀中小企业。推进新兴产业专业园区建设、打造重点拟上市后备库、承办第十二届APEC技展会……通过不同纬度将中小企业推到舞台中央,为资本筛选出优质的投资标的。
同时,青岛亦不断升级创投风投支持举措,为本土企业创造更好的融资环境。2023年5月,青岛发布“创投风投十条”政策3.0版,在保持原政策部分奖励的基础上,重点增设机构规模奖励、资本招商奖励以及S基金交易奖补,吸引多元资本入局。同时促进创投风投机构与实体经济对接,为科技创新、制造业转型升级、提振消费等行业提供澎湃动能。
历经四年的潜心磨砺,青岛已显露出创投风投产业集群的蓬勃之力。2019年以来,全市新增46家上市公司,数量超过前25年的总和。截至2023年底,全市境内外上市公司总数达85家,其中境内上市公司67家,稳居省内第一、北方第三。
作为直接融资的重要途径,一级市场融资规模和效率对实体经济发展至关重要。但也同样不能忽视,北方地区的资本活跃度和获投企业数量与南方省份还存在较大差距。2023年,广东、江苏、浙江地区的投融资案例数均逾800起,超过山东省数倍。这也意味着,作为山东省龙头城市,青岛在前期收获的中小企业培育和资本市场活跃度成果之上,还有更重的责任与更大的空间。(青岛日报/观海新闻记者 丁倩倩)

青岛日报2024年1月18日6版